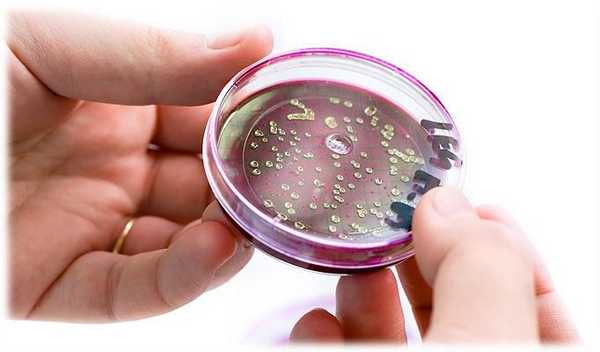
общие сведения о дисбактериозе и его лечении

Современные представления о микрофлоре человека: что такое дисбактериоз?
Добавил пользователь Дмитрий К. Обновлено: 11.12.2025
Методические рекомендации предназначены для системы последипломного профессионального образования врачей. Посвящены общеклинической проблеме - дисбактериозу кишечника. Рассматриваются вопросы этиологии, патогенеза, клиники, диагностики и лечения дисбактериоза кишечника. Особое внимание уделено рациональному использованию пробиотиков и, в частности, Йогулакта в терапии данной патологии.
Количественные и качественные нарушения нормальной микрофлоры традиционно относят к понятию "дисбактериоз". В последнее время широко используется термин "дисбиоз кишечника", образованный из латинских слов "dis" - затруднение, нарушение, расстройство и "bios" - жизнь. Дисбиоз - это нарушение функционирования и механизмов взаимодействия организма человека, его микрофлоры и окружающей среды. Дисбактериоз кишечника всегда вторичен и представляет собой клинико-лабораторный синдром, который развивается при целом ряде заболеваний и клинических ситуаций и характеризуется изменением качественного и/или количественного состава микрофлоры определенного биотопа, транслокацией различных ее представителей в несвойственные биотопы, а также метаболическими и иммунными нарушениями, сопровождающимися у части пациентов клиническими симптомами.
Термин "дисбактериоз" был введен в клиническую практику в 1916 году немецким врачом А.Ниссле для обозначения явлений бродильной и гнилостной диспепсии. Существуют различные интерпретации этого термина.
Определение дисбактериоза.
В литературе рассматривается ряд определений дисбактериоза.
Дисбактериоз - это изменение количественного и (или) качественного состава бактериальной флоры, обусловленное динамическими нарушениями микроэкологии кишечника в результате расстройства адаптационных, защитных и компенсаторных механизмов. Микробиологически дисбиоз выражается в снижении количества облигатной флоры в кишечнике (бифидо - и лактобактерий, кишечной палочки)[Архипов Г.С., Венгеров Ю.Я., 2009].
За рубежом чаще используют термин "синдром избыточного бактериального роста" в тонкой кишке (СИБР). Его определение носит более конкретный характер, и постановка диагноза базируется на обнаружение более 10 5 микроорганизмов в одном мл аспирата из тощей кишки и/или появление флоры, характерной для толстой кишки
В последние годы проблема дисбактериоза вызывает немало дискуссий у специалистов различного профиля - клиницистов и бактериологов. Необходимо отдавать себе отчет в том, что, по мнению многих, такой нозологической единицы не существует, хотя в отечественных публикациях часто встречаются термины "дисбактериоз" или "дисбиоз кишечника". Дисбактериоз описывают даже в качестве самостоятельного заболевания, однако в существующих международных классификациях болезней он отсутствует. Некоторые авторы подчеркивают, что дисбактериоз или дисбиоз - не заболевание, а отклонение от нормы одного из параметров гомеостаза, который зачастую не требует обязательного лечения. Он всегда вторичен и причинно обусловлен. Данная точка зрения имеет важное практическое значение, так как исключает принадлежность дисбактериоза к самостоятельным болезням человека. В то же время сама возможность наличия такого патологического состояния, как дисбактериоз, никем не отрицается, так как в основе его развития лежат многообразные изменения в качественном и количественном составе микрофлоры пищеварительного тракта [Шендеров А.Б., 2000].
Эпидемиология дисбактериоза кишечника.
По данным РАМН более 90% населения России в той или иной мере страдает дисбактериозом. По данным зарубежных исследователей все жители планеты на протяжении жизни имеют те или иные отклонения от нормобиоценоза.
Роль нормальной микрофлоры кишечника в поддержании гомеостаза.
Нормальная микрофлора - эволюционно сложившаяся экологическая система симбиотических микроорганизмов, населяющих открытые полости человека и поддерживающие метаболическое, биохимическое и иммунологическое равновесие, необходимое для здоровья человека [Бондаренко В.М., 2007]. Микробиота кишечника взрослого содержит 10 - 100 триллионов микробов, общей массой от 1 до 2,5 кг. На жизнедеятельность кишечной микрофлоры расходуется до 10% поступившей энергии и 20% объема принятой человеком пищи. В толстой кишке содержится около 1,5 кг различных микроорганизмов. В 1 грамме содержимого слепой кишки обнаруживают около 2 миллиардов микробных клеток (представители 17 семейств, 45 родов, 500 видов). Плотность заселения микроорганизмами увеличивается к дистальному отделу тонкой кишки, резко возрастает в толстой кишке, достигая максимальных значений на уровне ободочной кишки. Толстая кишка человека в наибольшей степени колонизирована микроорганизмами. Количество бактерий в фекалиях может достигать 5х10 12 КОЕ/г содержимого (количество образующих колонии микроорганизмов - колониеобразующих единиц - на 1 грамм фекалий). В прямой кишке плотность обсеменения составляет до 400 миллиардов бактерий на 1 грамм содержимого.
Доминирующей группой, характерной для эубиоза здоровых взрослых людей, являются анаэробные бактерии, на долю которых приходится до 90-98% от общего количества микроорганизмов кишечника. Анаэробными являются микробы, способные существовать без свободного кислорода.
В отличие от них, жизнедеятельность аэробной флоры возможна только при наличии свободного кислорода. Аэробные и условно анаэробные бактерии, представленные кишечными палочками, стрептококками, энтерококками, составляют в сумме не более 5-10% от всей заселяющей кишечника человека аутофлоры.
Соотношение между кишечными анаэробами и аэробами в норме составляет 10:1.
В таблице 1 приведен состав представителей аэробной и анаэробной микрофлоры
Таблица 1. Состав аэробной и анаэробной микрофлоры
Классификация нормальной микрофлоры толстой кишки здорового человека
Нормальная микрофлора кишечника по количественным соотношениям представлена тремя основными группами:
1. Основная или облигатная микрофлора. Обязательная для толстой кишки. Это, преимущественно, грамположительные бесспоровые анаэробы - бифидобактерии и грамотрицательные бактероиды. Составляет 90-95% микробиоценоза человека.
2. Сопутствующая микрофлора. Представлена, в основном, аэробами - лактобактерии, кокковые формы, кишечная палочка (E.coli). В сумме эти микроорганизмы не превышают 5% микробиоценоза. Лактобактерии и E.coli являются синергистами бифидобактерий.
3. Остаточная микрофлора (условно-патогенная или факультативная микрофлора). К этой группе относятся стафилококки, кандиды, протей, синегнойная палочка, энтеробактерии, кампилобактерии. Удельный вес этой группы в норме не превышает 1% от общего количества микроорганизмов.
В зависимости от времени присутствия бактерий в кишечнике: постоянного или периодического, микрофлору здоровых людей подразделяют на несколько видов:
По локализации в кишечнике микроорганизмы можно также разделить на следующие две группы, отличающиеся друг от друга по количественной и качественной характеристикам:
В зависимости от расщепляемых микрофлорой пищевых веществ бактерии разделяют на:
Пристеночная (мукозная) микрофлора включает с себя более 395 филогенетически обособленных групп микроорганизмов [Бондаренко В.М., 2007]. Мукозная микрофлора (пристеночно) формирует микроколонии, образующие биопленку. Биопленка - микробное сообщество, которое как бактериальный газон выстилает поверхность слизистых. Генная структура микрофлоры тождественна генной структуре макроорганизма [Конев Ю.В. и соавт. , 2001]. В микробно-тканевом комплексе (биопленке) происходит распознавание и обмен генетическим материалом поступающих в желудочно-кишечный тракт (ЖКТ) микроорганизмов (в том числе, в составе пробиотиков). Распознавание молекулярного образа патогенных и симбиотических микроорганизмов - ключевой момент межмикробного взаимодействия. Он определяет молекулярно-генетическую и метаболическую биосовместимость нормофлоры с пробиотиками.
При рассмотрении многогранной функции нормальной микрофлоры кишечника необходимо использовать термин "энтеральная среда". Она представляет собой сложную систему жидкостей, включающую пищу, ее компоненты, пищеварительные секреты, кишечную микрофлору макроорганизма и ее метаболиты [Щекина М.И., 2009]. Сбалансированное существование энтеральной среды жизненно важно как для самого макроорганизма, так и симбионтной микрофлоры, присутствующей в кишечнике.
С этих позиций представляется целесообразным выделить наиболее значимые функции нормальной микрофлоры желудочно-кишечного тракта (ЖКТ) [Архипов Г.С., Венгеров Ю.Я., 2009]:
- Участие в пищеварении:
- переваривание полисахаридов (пектин, микрополисахариды, гликопротеиды);
- расщепление непереваренных азотсодержащих соединений, мочевины;
- синтез некоторых незаменимых аминокислот;
- деконьюгация желчных кислот;
- детоксикация ксенобиотиков (лекарственных веществ, токсических веществ, консервантов).
- Синтез витаминов. Микрофлора - основной источник витамина К, витаминов группы В (цианкобаламин, фолиевая кислота, биотин, рибовлавин, пантотеновая кислота).
- Защитные функции :
- колонизационная резистентность: связывание с рецепторами и заселение слизистого слоя кишечника;
- синтез бактерицидных веществ: летучих жирных кислот, перекиси водорода, сероводорода;
- конкуренция с транзиторной микрофлорой за питательные вещества;
- снижение внутриполостной рН;
- стимуляция местного иммунитета: выработка иммуноглобулинов и неспецифических факторов защиты (лизоцим, интерферон);
- поддержание реакций клеточного иммунитета.
- Расширение наследственной программы: обмен регуляторными молекулами, фрагментами структурных генов с другими представителями микробиоценоза.
- Обеспечение трофического гомеостаза. Нормальная микрофлора кишечника является клеточным, метаболическим, иммунологическим и генетическим компонентом жизнедеятельности человека.
Рассмотрим функции микрофлоры подробнее.
Известно, что основной функцией нормальной микрофлоры человека является обеспечение колонизационной резистентности (КР) пищеварительного тракта. В обычных условиях поддержание КР микрофлорой осуществляется за счет продукции антибиотических веществ, конкуренции за места адгезии, подавления адгезии условно патогенных бактерий, ингибирования транслокации и ряда опосредованных механизмов.
Участие в пищеварении является важным звеном деятельности микрофлоры кишечника. Симбионты в качестве промежуточных продуктов бактериального гидролиза пищи образуют янтарную, уксусную, масляную, пропионовую, муравьиную и другие кислоты, а также ряд газов, включая водород, диоксид углерода, метан. В норме происходит практически полная активная утилизация этих токсических метаболитов самой микрофлорой. При этом бифидо -, лактобактерии и энтерококки расщепляют целлюлозу и гемицеллюлозу с образованием короткоцепочечных жирных кислот. Кишечная палочка, бактероиды, клостридии и протей метаболизируют протеины до аммония, фенолов и меркаптопурина. При сбалансированном микробиоценозе эти процессы равновесны. Анаэробная микрофлора трансформирует пищевые волокна с образованием крайне важных для организма сахаров, аминокислот и минеральных веществ (табл. 1)
Таблица 2. Влияние продуцируемой микрофлорой низкомолекулярных метаболитов на функции организма (Щекина М.И., 2009)
| Метаболиты микрофлоры | Физиологические эффекты |
| Оксид азота | Регуляция моторной активности кишечника Регуляция нейротрасмиссии Регуляция сосудистого тонуса Антиоксидантное действие Антиапоптическое действие |
| Глутамат | Влияние на процессы нейрорегуляции |
| Изовалериановая, изокапроновая кислоты | Индукция секреции инсулина |
| Ацетат | Субстрат гипогенеза |
| Бутират | Регуляция пролиферации и дифференцировки колоноцитов Влияние на моторику толстой кишки |
| Эстрогеноподобные вещества | Влияние на пролиферацию эпителия (изменение экспрессии генов) |
| Сигнальные молекулы | Позволяют иммунной системе человека распознавать эти микроорганизмы как "свои" |
Микрофлора кишечника участвует в деконьюгации желчных кислот. 80-95% желчных кислот реабсорбируются, остальные под действием бактериальных ферментов в комплексе с холестерином превращаются в нерастворимые соединения и выделяются с каловыми массами. Выраженными холестеринснижающей активностью обладают бифидо- и лактобактерии, уменьшающие растворимость холестерина.
Нормальная микрофлора участвует в синтезе основных витаминов группы В (В1,В2,В6,В8,В12), витаминах К, С, никотиновой, фолиевой, пантотеновой, липоевой кислот. Доминирующее позиции в этом плане занимает кишечная палочка, обеспечивающая синтез 9 витаминов.
Функционирование обширной и активированной иммунной системы кишечника зависит от наличия нормальной микрофлоры. При этом иммунная система кишечника у здоровых людей регулируется таким образом, чтобы избежать чрезмерного кишечного ответа на пищевые антигены и кишечные бактерии-комменсалы. Отличительной особенностью мукозной иммунной системы пищеварительного тракта является лимфоидная ткань, представленная пейеровыми бляшками. При активации Т- и В- клетки пейеровых бляшек, мигрируют в кровь и экспрессируют α4β7-интегрин. Способность лимфоцитов мигрировать из кровеносных сосудов в собственную пластинку достигается при экспрессии лиганда к α4β7-интегрину на эндотелиальных клетках сосудов кишечника [Campbell D.J. et al.,2003]. Посредством данного механизма хемокины, вырабатываемые эпителиальными клетками, регулируют миграцию лимфоцитов в ткани кишечника.
Кишечная микрофлора обеспечивает активацию специфического клеточного и гуморального иммунитета, а также стимулирует неспецифическую резистентность организма. Сложившийся микробиоценоз кишечника стимулирует продукцию IgА и секреторного IgА, участвующего в локальной защите слизистой оболочки кишечника от патогенных вирусов, бактерий, токсинов и аллергенов. Микрофлора кишечника активирует фагоцитарную активность макрофагов и нейтрофилов. Нормофлора стимулирует созревание лимфоидного аппарата, потенцируя продукцию интерферона и лизоцима. Лакто- и бифидобактерии повышают фагоцитарную активность гранулоцитов крови, стимулируют продукцию цитокинов мононуклеарами, нормализуют иммунорегуляторный индекс, синтезируют ряд биологически активных веществ, разрушающих антигены.
Для нормального развития мукозного иммунного ответа необходимо наличие в кишечнике бактерий-комменсалов, при этом мукозная иммунная система распознает их постоянно, обеспечивая толерантность и контролируя воспаление [Broad A. et. al., 2006]. Кишечный эпителий определяет присутствие бактерий-комменсалов через паттерн-распознающие рецепторы, к которым относятся Тoll-подобные (ТПР) и внутриклеточные NOD-подобные рецепторы. Паттерн-распознающие рецепторы идентифицируют структуру бактерий и вирусов и запускают провоспалительные механизмы путем активации транскрипционного ядерного транскрипционного фактора kВ (NF-kB) [Macdonald T.T., Monteleone G., 2005].. В норме активация ТПР сопровождается усиление естественной резистентности, обеспечивающей гомеостаз желудочно-кишечного тракта и дает возможность избежать проникновения патогенных бактерий и повреждения эпителия.
Нормальная микрофлора кишечника обеспечивает трофический гомеостаз, влияя на регенераторные процессы в слизистой оболочки кишечника. Так, бифидо- и лактобактерии повышают митотическую активность энтероцитов крипт. Представители нормальной кишечной флоры синтезируют короткоцепочечные жирные кислоты, которые являясь энергетическим субстратом окисления в цикле Кребса, оказываю благотворное влияние на трофику и клеточную регенерацию слизистой оболочки кишечника и других тканей организма.
Нормальная кишечная микрофлора участвует в нейтрализации экзогенных и эндогенных метаболитов (нитратов, ксенобиотиков, мутагенных стероидов, токсичных продуктов белкового обмена - индола, скатола, фенола)
Дисбактериоз кишечника
В норме в желудочно-кишечном тракте проживает масса бактерий, которые выполняют самые разнообразные полезные функции: расщепляют растительную клетчатку, синтезируют витамины группы В, сдерживают размножение патогенных микроорганизмов и др. При дисбактериозе происходит изменение качественного и количественного состава микрофлоры кишечника - популяция полезных бифидо- и лактобактерий существенно уменьшается, а количество патогенных микроорганизмов растет.
Причины дисбактериоза кишечника
- длительный бесконтрольный прием антибиотиков;
- перенесенная острая кишечная инфекция;
- несбалансированное питание;
- хронические заболевания желудочно-кишечного тракта;
- злоупотребление алкоголем;
- тяжелые иммунодефициты (при лейкозе, СПИДе, лечении злокачественных опухолей лучевой и химиотерапией).
Симптомы дисбактериоза кишечника
Симптомы и проявления обычно связаны с заболеванием или состоянием, которое вызвало дисбактериоз, и являются неспецифичными:
- чувство дискомфорта в животе;
- повышенное газообразование (метеоризм);
- изменения стула (поносы, запоры или неустойчивый стул); .
Что можете сделать Вы
Лечение дисбактериоза - это длительный процесс. Поэтому ваша основная задача скрупулезно соблюдать назначения врача.
Лечение
Что может сделать врач
Диагностикой и лечением дисбактериоза, как правило, занимается терапевт. Для постановки диагноза требуется наличие определенной клинической картины, а также результаты следующих анализов: копрограмма (общий анализ кала) и микробиологический посев кала. Но для назначения грамотного лечения необходимо не только установить наличие дисбактериоза, но и выявить его причину. В каждом конкретном случае могут потребоваться разный набор дополнительных исследований.
Лекарственные препараты, используемые при дисбактериозе, разделяют на пробиотики и пребиотики.
Пробиотики содержат в себе живые микроорганизмы - молочнокислые бактерии, чаще бифидо- или лактобактерии, которые относятся к нормальным обитателям кишечника здорового человека. Пребиотики - это вещества, создающие среду для роста полезных бактерий. В большинстве случаев для лечения дисбактериоза бывает достаточно вновь заселить кишечник здоровой микрофлорой. А она сама победит патогенные микроорганизмы. Иногда все же для борьбы с патогенной флорой приходится использовать антибиотики. Лечение проводится не менее 4-6 недель с последующим контролем эффективности терапии.
Профилактика
Немаловажное значение для профилактики дисбактериоза имеет рациональный режим питания и сбалансированный состав пищи. При назначении антибиотиков параллельно рекомендуется применять препараты, поддерживающие рост и развитие нормальной микрофлоры. Будущим мамам следует знать, что вскармливание грудным молоком защищает малышей от дисбактериоза с самого рождения.
Современные представления о микрофлоре человека: что такое дисбактериоз?
В 1681 году А.В.Левенгук сделал эпохальное научное открытие. Он обнаружил микроорганизмы в фекалиях и выдвинул гипотезу о совместном существовании различных видов микроорганизмов в желудочно-кишечном тракте (ЖКТ). В дальнейшем воззрения на микрофлору человека менялись. От негативного мнения И.И.Мечникова, представлявшего причину инфекционных болезней совокупным воздействием на организм токсинов бактерий пищеварительного тракта, до резко позитивного мнения о той пользе, которую получает человек от совместного существования организма и бактерий.
В настоящее время микрофлору кишечника рассматривают как самостоятельный дополнительный многоклеточный орган, участвующий в гомеостазе - динамическом постоянстве внутренней среды организма, обеспечивающей сбалансированную работу всех органов и систем. Общая численность микроорганизмов, обитающих в различных отделах человеческого организма 10 15 (100 трлн) на 2 порядка больше, чем клеток человека. Вес нормальной микрофлоры составляет 5-6% веса организма. Из них 60% находится в желудочно-кишечном тракте, 15% - в респираторном тракте, 11% - в мочеполовой системе, 14% - на кожных покровах человека. В толстой кишке обитает более 1000 видов микробов. Причем, общее количество генов кишечной микробиоты (совокупности бактерий, вирусов, грибков и простейших, заселяющих полости и покровы человека) ~ 10 6 ,что на 2 порядка больше, чем генов человека.
Нормальная микробиота кишечника - это1 800 родов и 15 000-36 000 видов бактерий. На питание микрофлоры расходуется около 20% питательных веществ, поступающих в кишечник и 10%, вырабатываемой организмом энергии.
Кишечная микрофлора состоит из двух взаимосвязанных популяций: полостная и пристеночная (мукозная) микрофлора. Мукозная микрофлора- это колонии бактерий, продуцируемые ими метаболиты, а также эпителиальные клетки, муцин бокаловидных клеток, фибробласты, лейкоциты, лимфоциты, иммунные клетки. Просветная микрофлора находится в просвете ЖКТ, не взаимодействует со слизистой оболочкой, более изменчива, зависит от поступления пищевых волокон. Нормальная микрофлора толстой кишки состоит из облигатной, факультативной и транзиторной флоры. Облигатная флора (постоянная), содержит бифидобактерии, лактобациллы, энтерококки, кишечную палочку, пропионибактерии, пептострептококки. Факультативная (непостоянная) - клостридии, стафилококки, протеи, дрожжеподобные грибы. Транзиторная (случайная) - синегнойную палочку, грибы рода Кандида, патогенные энтеробактерии.
Микрофлора желудочно-кишечного тракта многообразна.
Микрофлора полости рта - стрептококки, лактобациллы, нейссерии, вейонеллы, фузобактерии, бактероиды, бифидобактерии, стафилококки, грибы, простейшие и др.Микрофлора желудка и 12-перстной кишки - стрептококки, лактобациллы, энтерококки. Микрофлора тонкой кишки - стрептококки, лактобациллы, бифидобактерии. Микрофлора толстой кишки содержит анаэробы: бифидобактерии, бактероиды, пропионибактерии, пептострептококки, вейонеллы, эубактерии, фузобактерии, катенобактерии; микроаэрофиллы: лактобациллы и аэробы: эшерихии, молочнокислый стрептококк, фекальные стрептококки, стафилококки.
В норме в бактериоценозе толстой кишки детей 90-95% общего количества микроорганизмов составляют бифидобактерии, а у взрослых их уже не более 10%.
Функции кишечной микрофлоры это: защитная, пищеварительная, детоксикационная, антиканцерогенная, иммуногенная, генетическая, функции регуляции обмена холестерина и синтеза витаминов.
Что же такое дисбактериоз и когда он возникает?
Дисбактериоз (дисбиоз) - клинико-микробиологический синдром, характеризующийся стойкими и выраженными изменениями качественного и/или количественного состава микрофлоры кишечника, неисчезающими после устранения неблагоприятного фактора, сопровождающийся расширением сферы ее обитания (заселением тонкой кишки) и нарушением кишечных функций. Дисбактериоз кишечника всегда вторичен, возникает, обычно, на фоне неблагоприятных внешних факторов и патологических состояний, и, следовательно, не может являться основным диагнозом.
Причины дисбактериоза кишечника различны и многообразны. К ним относятся нерациональное питание и нерациональная антибиотикотерапия, хронические заболевания ЖКТ, острые инфекционные заболевания ЖКТ, гнойно-инфекционные заболевания, иммуннодефицитные состояния, стрессы.
Пути поддержки и коррекции кишечной микрофлоры: устранение причин дисбактериоза, пребиотики в питании, пробиотики в составе продуктов, пробиотики в составе препаратов, для младенцев - сохранение грудного вскармливания.
Пробиотики - препараты (лекарства), состоящие из живых непатогенных микроорганизмов. Существуют различные типы пробиотиков:
- монокомпонентные (бифидумбактерин, лактобактерин);
- поликомпонентные или симбиотики, содержащие несколько штаммов или видов бактерий (линекс);
- комбинированные - синбиотики, содержащие бактерии и ингредиенты, способствующие их росту или размножению (аципол, кипацид, нормоспектрум, бифидум-мульти);
- поликомпонентные комбинированные - симбиотик+синбиотик (бифиформ, бион);
- конкурентного действия, вытесняющие условно-патогенные и патогенные микробы (энтерол, бактисубтил, биоспорин, бактистатин).
Пребиотики - лекарственные средства, пищевые волокна или добавки к пище, не содержащие живых микроорганизмов, стимулирующие рост или размножение нормальной микрофлоры:
- олигосахариды - крупы, фасоль, молочные продукты;
- инулин - топинамбур, артишок, одуванчик; - дюфалак, нормазе.
Решение проблемы дисбактериоза связано с необходимостью оберегать собственную микрофлору, способствовать улучшению экологии, питания, рациональному применению антибиотиков и других лекарственных средств.
Современные представления о микрофлоре человека: что такое дисбактериоз? : применяемые препараты безрецептурного отпуска 2
Общие сведения о дисбактериозе
Дисбактериоз (также дисбиоз) — представляет собой состояние микробного дисбаланса на теле или внутри него. При этом сам по себе дисбактериоз не является болезнью, но может иногда являться следствием какой-либо болезни.
Дисбиоз кишечника как правило связывают с различными заболеваниями, такими как воспалительное расстройство кишечника, поскольку при воспалении кишечника может возникать дисбаланс кишечной микрофлоры , или синдром хронической усталости .
В России под дисбактериозом обычно понимают дисбактериоз кишечника, определенный в приказе Минздрава 2003 года как «клинико-лабораторный синдром, связанный с изменением качественного и/или количественного состава микрофлоры кишечника».
В теле взрослого человека, в зависимости от массы, живет от 3 до 5 килограммов бактерий, у ребенка до 1,5 килограмм. 60% всех микроорганизмов расселены в ЖКТ. Этот огромный мир микроорганизмов превышает геном человека в десять раз, участвует в работе иммунной системы, стимулируя выработку иммуноглобулинов. Микроорганизмы выполняют важные функции : помогают переваривать пищу, синтезируют витамины, выводят токсины и канцерогенные вещества, участвуют в водно-солевом обмене, регуляции желчных кислот, стероидов и т.д., подавляют рост патогенов .
Но бывают случаи, когда «полезных» микроорганизмов становится мало, и «вредные» начинают активно размножаться, снижая иммунитет и отравляя органы человека. Кишечная микрофлора превращается в гнилостную, возбуждая воспалительные процессы кишечника. Такая флора становится хорошей основой для развития опасных заболеваний, вплоть до рака.
Виды и степени кишечного дисбактериоза
В зависимости от причины возникновения синдром кишечного дисбактериоза в современной медицине подразделяется на несколько видов.
- Дисбактериоз, возникающий у здоровых людей:
- Профессиональный (нарушения происходят из-за вредной профессиональной деятельности)
- Возрастной (флора нарушается по причине старения организма)
- Нутритивный (связан с неправильным питанием)
- Сезонный (флора меняется в зависимости от времени года, преимущественно в холодное время).
Дисбактериоз, возникающий при заболеваниях пищеварительных органов:
- Проблемы в желудке с понижением кислотности
- Болезни поджелудочной железы
- Заболевание желчевыводящих протоков и печени
- Различные заболевания толстого и тонкого кишечника
- Признаки мальбабсорбции (дисбаланс ферментов, приводящий к неправильному перевариванию пищи)
Дисбактериоз, сопровождающий другие заболевания:
- инфекции
- аллергии
- иммунодефицитные состояния
- гиповитаминозы
- стрессы
- лекарственный дисбактериоз (вызывается приемом фармацевтических препаратов)
- дисбактериоз, вследствие гипоксии (нехватки кислорода)
Степени дисбактериоза также различны:
I степень — обусловлена снижением количества « полезных » микроорганизмов
II степень - увеличение условно-патогенных бактерий, которые способны проявлять агрессию
III степень - наличие большого количества агрессивных условно-патогенных бактерий
IV степень - полное отсутствие полезных бифидобактерий
Причины возникновения
Причинами ослабления полезной флоры кишечника могут послужить следующие факторы:
- Антибиотики. Попадание антибиотиков в кишечный тракт усиливает размножение патогенных микробов и грибов. Особенно сильно, дисбактериоз проявляется после приема антибиотиков широкого действия.
- Несбалансированное питание. Неправильный рацион приводит к дисбалансу флоры в том случае, если в пище преобладают животные белки и жиры, при этом кисломолочные продукты, свежие фрукты и овощи отсутствуют. Процессы гниения и брожения вызывают гибель нормальной флоры и развития патогенных бактерий.
- Радиационное лечение, химиотерапия. Сильнодействующие лечебные процедуры сильно снижают иммунную систему, в результате чего нормальная флора в кишечнике нарушается.
- Острые инфекции кишечника. Например, дизентерия , убивает полезную флору, помогая развиваться вредным бактериям.
- Паразиты в ЖКТ. Например, аскариды , выделяют токсины, убивающие нормальные микроорганизмы.
- Состояния, ослабляющие иммунную систему. Серьезные заболевания (онкология, сахарный диабет), старики и дети.
Симптомы дисбактериоза у взрослых
Симптомы дисбактериоза отличаются разнообразием, и у каждого взрослого человека проявляются по-своему. Первая и вторая степени, чаще всего клинически себя не проявляют. При третьей и четвертой степени нарушения флоры кишечника, характерными признаками являются:
- Нарушение стула. Часто проявляется в виде поноса, развивающегося из-за образования большого количества желчи и усиленной перистальтики кишечника. Спустя некоторое время в стуле приобретает гнилостный запах, с частицами слизи или крови.
- Запор. В престарелом и детском возрасте синдром развивается в виде запора. Так как из-за недостатка нормальной флоры перистальтика кишечника ослабевает.
- Вздутие живота. Вредоносные микроорганизмы выделяют газ, который скапливается в кишечнике и нарушает всасывательные функции, вызывает боль и неприятные журчащие звуки.
- Боль в виде схваток. Такой характер болей связан с давлением на стенки кишечника. После отхождения газов боль уменьшается. При воспалении тонкого кишечника боль локализуется в районе пупка, если страдает толстый кишечник - болит нижняя часть живота.
- Тошнота, рвота. Эти симптомы возникают из-за нарушенного пищеварения.
- Аллергия. Высыпания на коже после приема пищи, которая раньше не вызывала подобных симптомов - следствие ослабления микрофлоры, защищающей организм от аллергических проявлений.
- Интоксикация. Общее недомогание, усталость, повышение температуры тела - результат скопления продуктов метаболизма.
Как проявляется заболевание у детей
Дисбактериоз у детей протекает так же, как и у взрослых. В первую очередь возникают поносы либо запоры (иногда их чередование). В кишечнике ощущаются колики и вздутие, отрыжка и неприятный запах изо рта. После еды наблюдается чувство распирания в желудке. Часто синдром протекает в виде молочницы в полости рта и поражения кожи. Недостаток витаминов и полезных веществ в организме способствует образованию заед в уголках рта. Из-за снижения иммунитета может возникнуть фурункулез, угревая сыпь, выпадение волос.
Диагностика дисбактериоза
Основными диагностическими методами определения дисбактериоза, являются микробиологическое и копрологическое исследование кала на дисбактериоз, а также исследование (более продвинутое) по методу хромато-масс-спктрометрии микробных маркеров.
Как вылечить дисбактериоз кишечника
Лечение дисбактериоза довольно длительная процедура, требующая комплексного подхода. Основным терапевтические мероприятия по восстановлению микрофлоры кишечника, являются:
- Специальная диета
- Ликвидация патогенных бактерий
- Расселение в кишечнике новых полезных микроорганизмов
- Укрепление иммунитета
Безусловно, присутствие в рационе питания человека пробиотических продуктов ( пробиотиков ), а также пребиотических компонентов (например, пищевых волокон ), является наиважнейшим фактором здоровой микрофлоры, а также одним из главных средств в профилактике и лечении дисбиотических состояний.
По теме оценки дисбактериоза см. также:
Будьте здоровы!
ССЫЛКИ К РАЗДЕЛУ О ПРЕПАРАТАХ ПРОБИОТИКАХ
Дисбактериоз
Дисбактериоз - это состояние, вызываемое нарушением микрофлоры кишечника, связанное с изменением видового состава бактерий. При дисбактериозе количество полезных бифидо и лактобактерий сокращается, а количество патогенных (болезнетворных) микроорганизмов возрастает. Патология сопутствует многим болезням органов пищеварения, длительному или неконтролируемому употреблению антибиотиков, иммунодепрессантов, воздействию вредных факторов окружающей среды. Проявляется запорами, поносами, плохим аппетитом, сном, болями в животе, кожными высыпаниями. В особо тяжелых случаях бактерии желудочно-кишечного тракта могут быть обнаружены в крови, что угрожает развитием сепсиса.
Общие сведения
Дисбактериоз (дисбиоз) кишечника - заболевание, характеризующееся патологическим изменением состава нормальной флоры кишечника, способствующее нарушению функционирования кишечника.
Причины
Дисбактериоз кишечника практически никогда не бывает первичной патологией, а развивается вследствие тех или иных нарушений работы органов или систем, либо под влиянием приема препаратов и веществ, негативно действующих на микроорганизмы.
- Ятрогенный дисбактериоз кишечника возникает вследствие приема лекарственных средств, подавляющих жизнедеятельность микроорганизмов (антибиотики, сульфаниламидные препараты, гормональные средства, цитостатики и др.). Также дисбактериоз может стать результатом оперативного вмешательства.
- Неправильное питание, недостаток в рационе необходимых компонентов, его несбалансированность, присутствие разного рода химических добавок, способствующих подавлению флоры, сбои в режиме питания, резкое изменение характера рациона.
- Психологические стрессы разного рода.
- Инфекционные заболевания кишечника.
- Другие заболевания пищеварительных органов (панкреатит, гепатит, гастрит и др.).
- Иммунные расстройства, эндокринные заболевания, нарушения обмена.
- Нарушение биоритмов, акклиматизация.
- Нарушение кишечной моторики.
Патогенез
В кишечнике взрослого человека в норме содержится порядка 2-3 кг различных микроорганизмов (около 500 видов). Это бактерии-симбиониты, принимающие непосредственное участие в акте пищеварения. В здоровом организме качественный и количественный индивидуальный состав микрофлоры пребывает в состоянии физиологического равновесия - нормобиоценоза (эубиоза). При изменениях в составе кишечной флоры разрушается это равновесие, что негативно сказывается на способности кишечника к пищеварению.
Нормальными функциями кишечника являются:
- трофическая функция - обеспечение организма питательными веществами;
- энергетическая функция - поставка АТФ, энергообесечение кишечного эпителия;
- перистальтическая функция - химическая регуляция перистальтики;
- регенеративная функция - участие в дифференциации клеток при обновлении эпителиальной выстилки кишечника;
- участие в поддержании ионного баланса;
- формирование газового состава в кишечнике;
- участие в биохимический процессах в кишечнике - деактивация ядов, активация лекарственных средств, образование биологически активных веществ, нейротрансмиттеров, сигнальных маркеров и др;
- защитная функция - участие в местном иммунитете, выработка иммуноглобулина, цитопротекция, обеспечение устойчивости эпителия к патогенным и канцерогенным факторам, захват вирусов, считывание геномов патологических микроорганизмов;
- участие в метаболизме белков, жиров, желчных кислот и многих других важнейших составляющих питания, синтез витаминов группы В, пантотеновой кислоты;
- поддержание постоянства физико-химической среды кишечника.
Симптомы дисбактериоза
- Диспепсический синдром - диарея (иногда - чередование запоров и поносов), метеоризм, вздутие живота, отрыжка и неприятный привкус во рту, урчание в кишечнике.
- У многиx (особенно у детей), страдающих кишечным дисбактериозом, возникают не характерные ранее аллергические реакций на продукты питания. Реакции могут быть как обычного аллергического характера (крапивница, кожный зуд, бронхоспазм, ангионевротический отек), так и кишечного (жидкий пенящийся стул, резкая боль в животе, тошнота вплоть до рвоты, понижение артериального давления).
- Синдром мальабсорбции - нарушение всасывания в кишечнике различных необходимых питательных веществ проявляется недостаточностью субстратов обмена - белково-энергетическая недостаточность, различные гиповитаминозы, в первую очередь, как правило, по группе витаминов В, анемия, нарушения ионного баланса, недостаточность кальция и др.
- Интоксикация организма - слабость, отсутствие аппетита, субфебрилитет, головные боли.
- Снижение иммунитета - учащение инфекционных заболеваний (ОРЗ, ОРВИ, герпес), грибковые заболевания.
Диагностика
Диагностику кишечного дисбактериоза в клинической гастроэнтерологии начинают с выявления характерных диспепсических нарушений на основании жалоб, проводят физикальный осмотр. При диагностике, как правило, симптомы дисбактериоза проявляются на фоне первичной патологии, либо таковая присутствует в анамнезе. Обязательно обращают внимание на имевшее место лечение препаратами, подавляющими микрофлору.
Наиболее специфичная методика лабораторной диагностики кишечного дисбактериоза - анализ на дисбактериоз и бакпосев кала. Дисбактериоз тонкого кишечника диагностируется с помощью бактериологического исследования соскоба или аспирата тощей кишки, но в силу трудоемкости эта методика применяется только в случаях сомнительности других диагностических критериев. Косвенные признаки дисбактериоза кишечника может продемонстрировать копрограмма, биохимия каловых масс, газо-жидкостный анализ.
Лечение дисбактериоза
Лечение осуществляется врачом-гастроэнтерологом и подразумевает терапию по нескольким направлениям - патогенетическое лечение (искоренение причины возникновения заболевания), коррекция возникшего патологического состояния пищеварения, снятие острых симптомов заболевания, укрепление защитных свойств и восстановление нормального биоценоза в кишечнике.
- Патогенетическая терапия направлена на первичную патологию, а также включает в себя меры по восстановлению моторных функций кишечника, снятие возникшего воспаления, проведение заместительной ферментной терапии.
- Больным кишечным дисбактериозом показана диета №4 (модификации в зависимости от состояния), способствующая нормализации деятельности кишечника, уменьшению активности гнилостных процессов. Питание должно быть тщательно сбалансировано по составу нутриентов и энергетической составляющей. Обязательно соблюдение баланса содержания белков, жиров, углеводов, снабжение организма витаминами и микроэлементами, достаточным количеством жидкости. Необходимо обращать внимание на режим питания, его соответствие биоритмам.
- Включение в рацион продуктов, содержащих пищевые волокна, живые бактериальные культуры.
- Коррекция состава микрофлоры с помощью селективных невсасывающихся антибактериальных препаратов (рифаксимин), кишечных антисептиков (нифуроксазид), препаратов, содержащих культуры-антагонисты патогенной кишечной флоры, бактериофаги.
- Для восстановления иммунитета применяют иммуномодуляторы (препараты эхинацеи, нуклеиновые кислоты и др.).
Восстановление нормальной микрофлоры проводят с помощью:
- пробиотиков (препаратов, содержащих живые культуры необходимых микроорганизмов);
- пребиотиков (веществ, способствующих росту и размножению полезной флоры);
- синбиотиков (комплексные препараты, содержащие как сами микроорганизмы, так и необходимые для их развития компоненты).
Прогноз и профилактика
При своевременном лечении прогноз благоприятный. Профилактика дисбактериоза кишечника для здоровых людей подразумевает правильное питание с соблюдением режима, присутствие в рационе продуктов, содержащих полезные микроорганизмы (кисломолочные продукты, вещества, содержащие бифидо- и ацидофильные бактерии, пища и напитки, на основе заквасок). Обязательна сбалансированность питания по составу необходимых организму веществ, витаминов и микроэлементов.
Для младенцев оптимальной профилактикой дисбактериоза является грудное вскармливание, формирующее нормобиоценоз и иммунитет ребенка. Грудное молоко имеет оптимальный состав пребиотиков для развития здоровой микрофлоры кишечника.
Поскольку дисбактериоз кишечника чаще всего возникает вследствие употребления лекарственных препаратов антибактериальнго действия, то в таких случаях профилактикой этого заболевания выступает рациональное назначение фармакологических средств, комплексный подход к лечению инфекций - назначение препаратов согласно проведенным антибиотикограммам, определенной степени резистентности того или иного возбудителя к антибиотикам, параллельный прием препаратов для коррекции биоценоза кишечника.
При длительном лечении антибиотиками обязательно включать в терапию специальную диету, содержащую продукты, богатые полезными бактериями, противогрибковую и иммуностимулирующую, а также антигистаминную терапию.
Читайте также:
- Характеристика митохондриального наследования. Особенности
- Гормональные пробы у женщин в гинекологии. Проба с прогестероном, хорионическим гонадотропином
- Рекомендации по удалению матки (гистерэктомии) при раке эндометрия
- Синдром Прингла (Pringle)
- Причины травматического шока. Механизмы развития травматического шока

